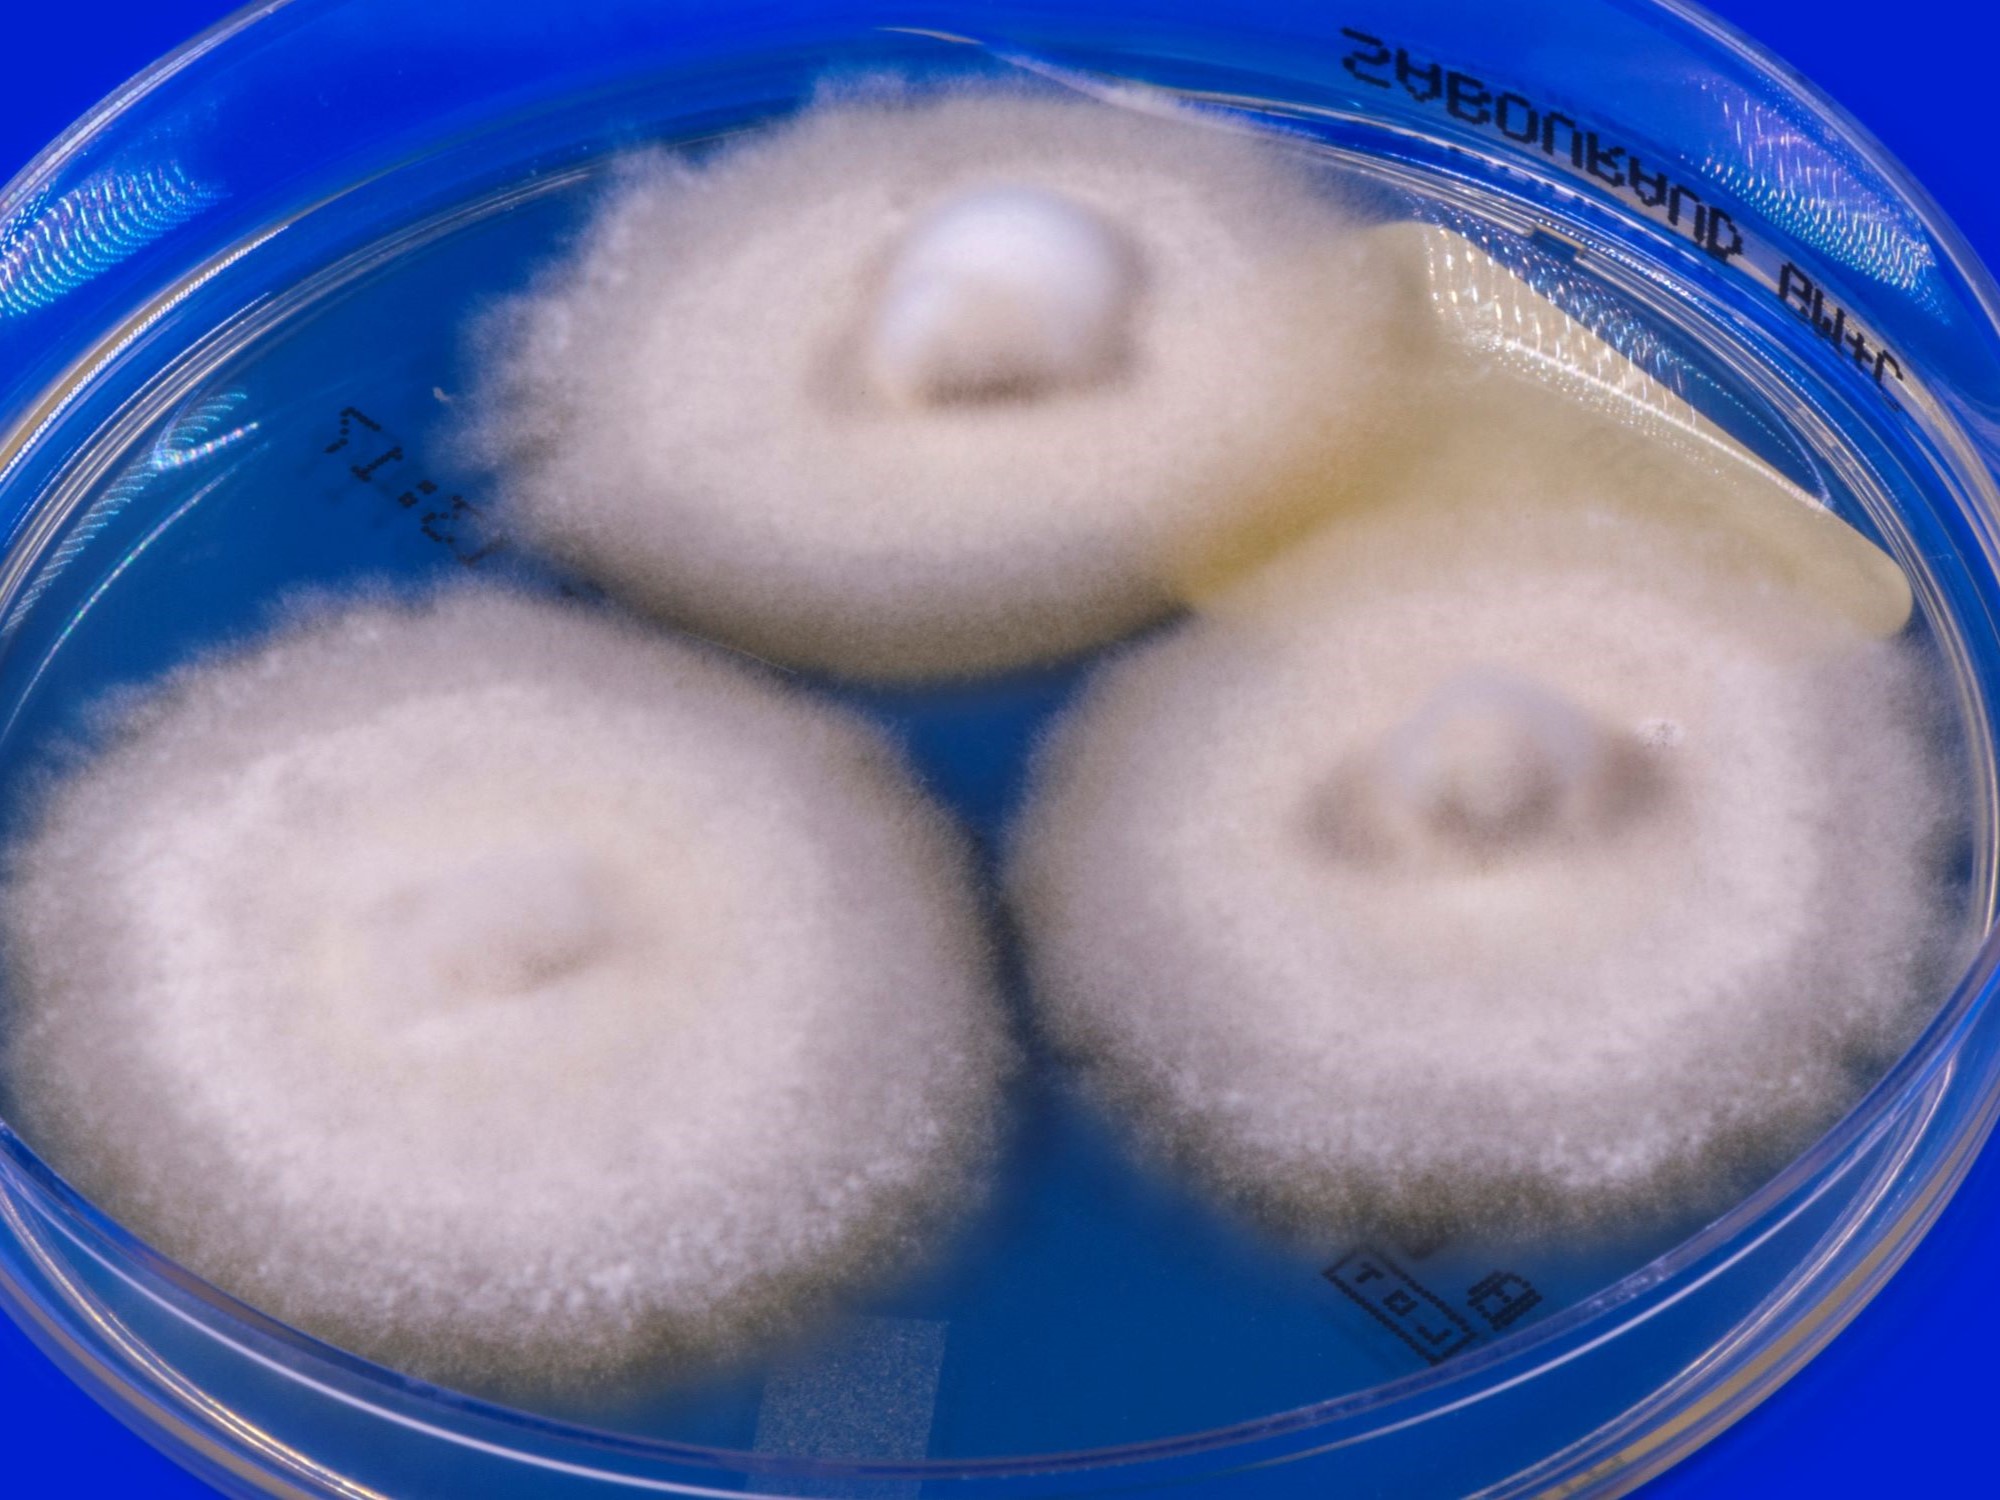
LABOPART Nannizzia perplicata

Les nanictidopidés (Nanictidopidae) forment une famille éteinte de thérapsides thérocéphales ayant vécu durant le Permien supérieur. Deux genres sont actuellement inclus dans cette famille, Nanictidops d’Afrique du Sud et Purlovia de Russie. Les nanictidopidés ont un crâne court et étaient probablement herbivores, contrairement à l'immense majorité des autres thérocéphales.
Description
Les nanictidopidés sont relativement gros par rapport aux autres thérocéphales, avec des crânes de 7 à 20 cm de long. Ils sont caractérisés par leurs crânes raccourcis qui semblent triangulaires lorsqu'ils sont vus d'en haut. La région temporale du crâne est très large. Ces crânes sont similaires à ceux de la famille des Hofmeyriidae (en) et la superfamille Nanictidopoidea a été créée pour unir ces deux groupes.
Les nanictidopidés ont des canines élargies aux mâchoires supérieure et inférieure, tandis que les dents derrière sont très petites. De petites bosses et des crêtes recouvrent des parties des mâchoires supérieures et inférieures. La région pariétale à l'arrière du crâne forme une crête sagittale. Les os post-orbitaires qui composent l'arrière des orbites sont très minces et n'enferment parfois pas toute l'orbite. Contrairement aux thérocéphales plus avancés, les nanictidopidés n'ont pas de palais secondaire.
Histoire et taxonomie
La famille Nanictidopidae a été nommé en 1956 par les paléontologues David Meredith Seares Watson et Alfred Sherwood Romer. Watson et Romer y ont inclus de nombreux genres de thérocéphales, notamment Blattoidealestes (en), Choerosaurus (en), Hofmeyria et Promoschorhynchus. Ces thérocéphales ont depuis été replacés dans d'autres familles comme les Hofmeyriidae (en) et les Akidnognathidae.
Paléobiologie
À part les canines, les nanictidopidés n'ont pas les grandes dents pointues des thérocéphales carnivores. On pense qu'ils étaient herbivores, mais ils n'ont pas les dents jugales élargies de la plupart des herbivores. Bien que leurs facettes d'usure indiquent une utilisation, la plupart de leurs dents sont petites et auraient joué peu de rôle dans le traitement des matières végétales. Une autre adaptation à l'herbivorie est le développement de plaques cornées sur le palais, mais les nanictidopidés ne montrent aucune trace de cette adaptation non plus. L'une des rares indications de régime provient d'une canine cassée et polie chez un spécimen de Purlovia. Cette dent pourrait avoir été usée pendant que l'animal creusait pour se nourrir. Les nanictidopidés étaient très probablement des herbivores primitifs, peut-être des mangeurs de fruits.
Notes et références
Notes
Références
Voir aussi
Articles connexes
- Therapsida
- Scylacosauria
Liens externes
- Ressources relatives au vivant :
- Paleobiology Database
- Global Biodiversity Information Facility
- Interim Register of Marine and Nonmarine Genera
- Portail de la paléontologie